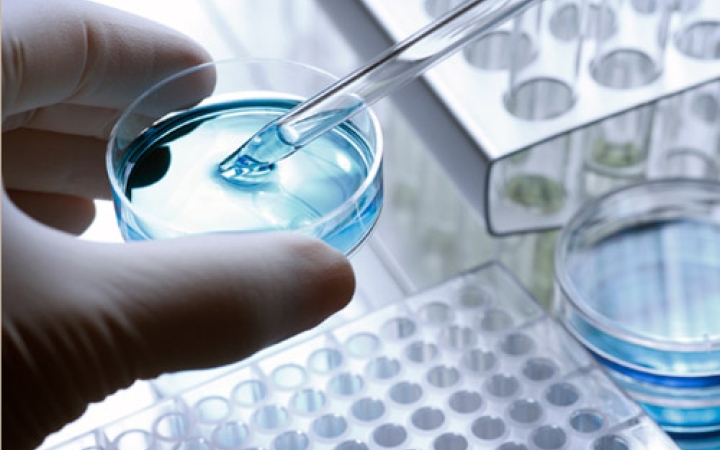
Megvan a rák ellenszere?

gyógyszer
Érdekességek a tüdőről
A tüdő egy nagyon fontos szervünk, mindenki tudja, hogy vigyázni kell rá, de mégsem tesszük. Nemcsak a dohányzás árthat neki, hanem a szmog, a különféle káros részecskék is, amelyek a levegőben találhatók. (X)
Ismerkedjünk meg közelebbről a süngombával!
Ha most azonnal egy cuki süni jelent meg a képzeletedben, akkor nem is jársz túl messze az igazságtól, hiszen ez a gomba bizony a tüskés megjelenéséről kapta a nevét. (X)
Koronavírus: marad a telefonos gyógyszerfelírás lehetősége
A gyógyszerfelírás továbbra is elintézhető lesz telefonon - közölte facebook-oldalán az emberi erőforrások minisztere szombaton. A tervek szerint szeptembertől állt volna vissza a régi rend, de nem fog.
Új hatóanyagot fejlesztettek ki a tartós izomgörcsök kezelésére Magyarországon
Új hatóanyagot fejlesztettek ki magyar szakemberek a stroke és más idegrendszeri betegségek után fellépő tartós izomgörcsök kezelésére - jelentette be az ELTE Motor Farmakológiai Kutatócsoportjának kutatásvezetője az M1 aktuális csatorna vasárnap délelőtti műsorában.
Törekedni kell a helyes antibiotikum-használatra
Törekedni kell a helyes antibiotikum-használatra az egészségügyi ellátás során, és ebben mind a lakosságnak, mind pedig a szakembereknek nagy szerepük és felelősségük van - mondta az egészségügyért felelős államtitkár hétfőn sajtótájékoztatón.
Megvan a rák ellenszere?
Egereken végzett immunkísérletek segítségével megtalálták a rák ellenszerét a Stanford egyetem kutatói. A gyógyszer két immunstimuláló szerből áll, melyek úgy fejtik ki hatásukat a T-sejtekre, hogy közben nem terhelik a beteg szervezetét - írja a hirado.hu.
Magyar agykutatók újabb óriási felfedezése
A Magyar Tudományos Akadémia kutatói és brit kollégáik kulcsfontosságú gyulladásos szenzorokat azonosítottak, amelyek jelentős szerepet játszanak a stroke-ot követően jelentkező idegrendszeri károsodás kialakulásában. Eredményük új utakat jelölhet ki a stroke kezelésében.